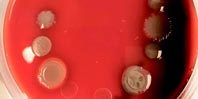
Компонент зубной пасты поможет победить опасную болезнь

Кистозный фиброз — наследственное заболевание, которое характеризуется поражением желез внешней секреции и тяжелыми нарушениями работы органов дыхания. При данной болезни в легких накапливается слизь. Она является идеальной средой обитания для бактерий. Убить бактерии сложно, так как они находятся под защитой особого барьера — биопленки. Поэтому болезнь процветает даже при лечении антибиотиками. Специалисты давно ищут способы уничтожения биопленок.
Для нового исследования ученые вырастили 6000 биопленок в чашках Петри. Затем в чашки добавляли тобрамицин вместе с другими соединениями. 25 соединений были эффективны, но триклозан выделялся среди остальных. Комбинация триклозана и тобрамицина лучше всего справлялась с биопленками. Тобрамицин используется для лечения кистозного фиброза, но один он, как правило, не очищает легкие от инфекции.
материал с сайта www.meddaily.ru